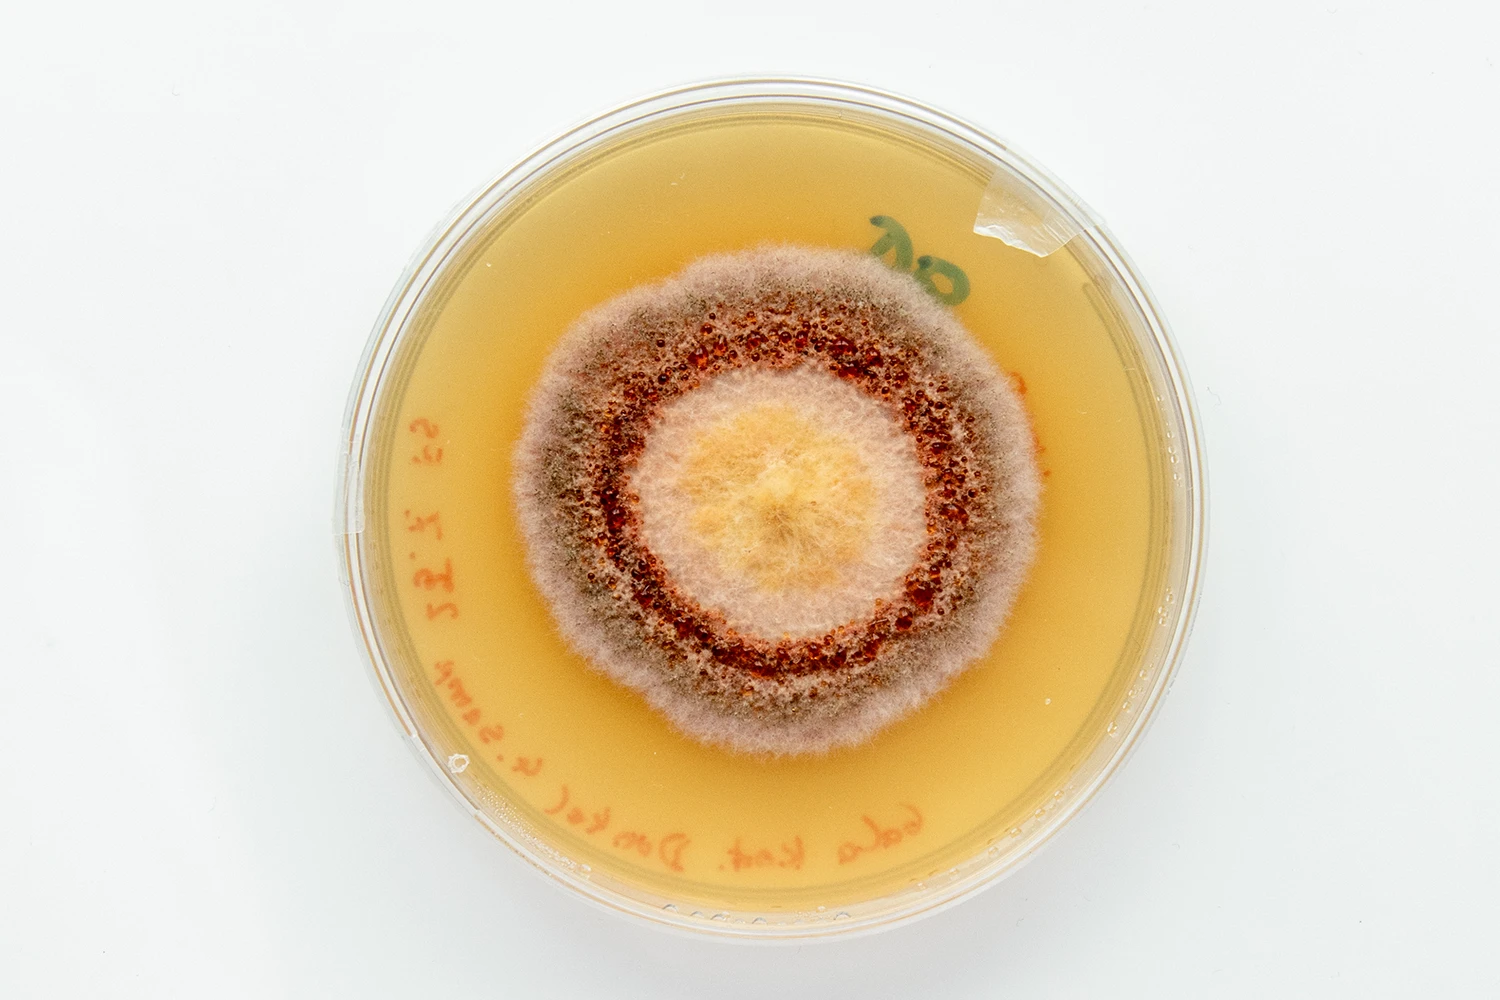
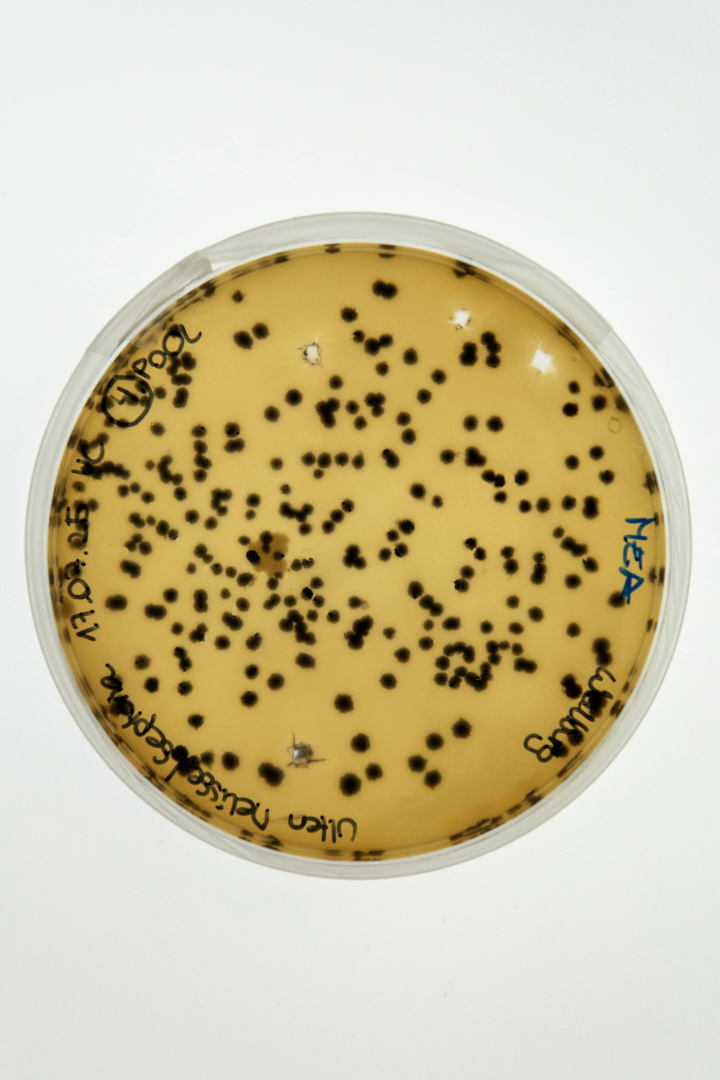
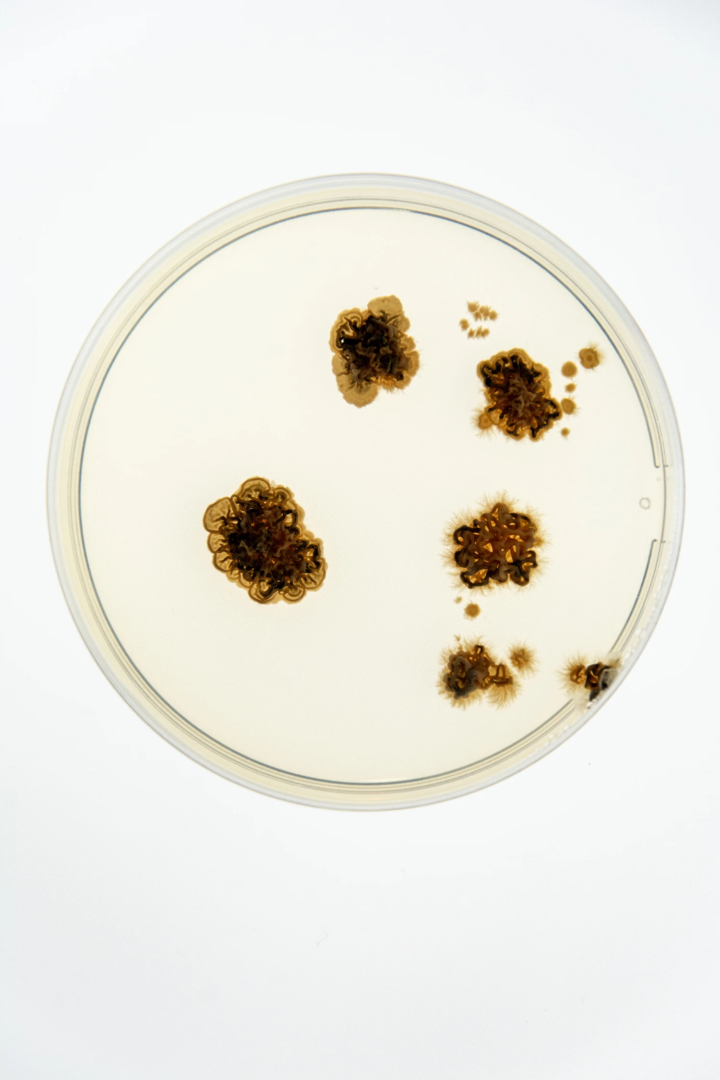
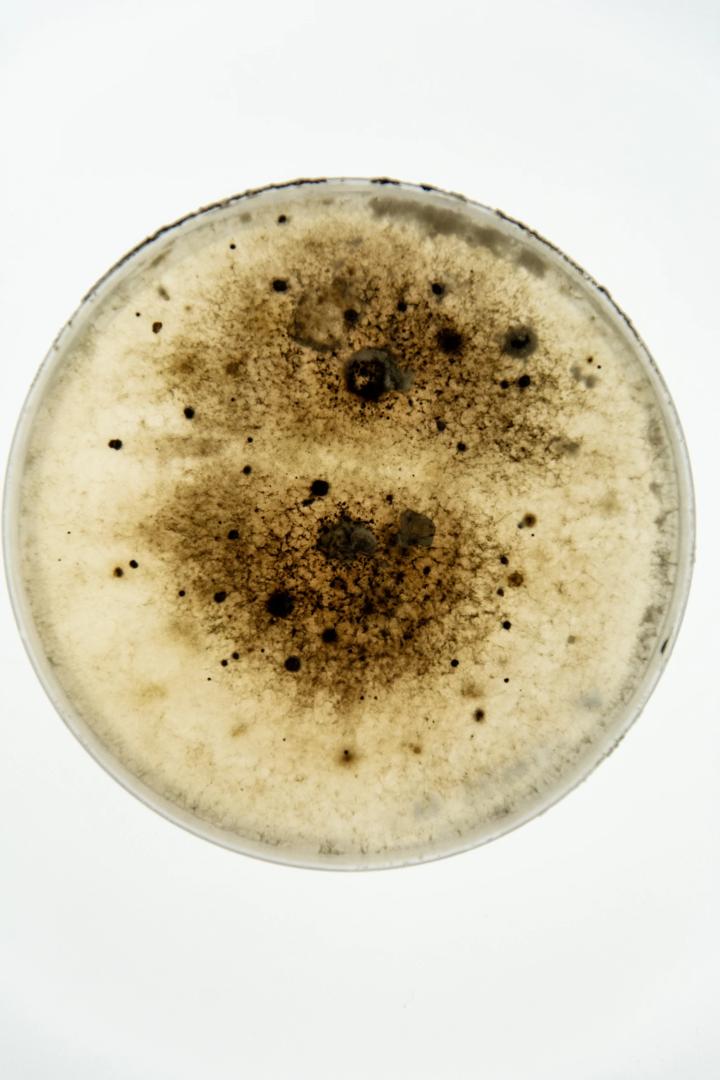

Ideonella sakaiensis: il batterio che degrada il PET può riscrivere il ciclo della plastica
La plastica, il materiale più “innaturale” che abbiamo creato, non è più immune alla vita: i ricercatori stanno studiando gruppi di batteri e funghi che, lavorando insieme, riescono a degradare anche le plastiche più resistenti
L’enigma dell’attrazione ripugnante: la muffa tra disgusto, paura e meraviglia
Vergogna. Disgusto. Morte. L’umanità ha cercato di nascondere vari aspetti della vita quotidiana — per decoro, paura o repulsione viscerale. La muffa è fra questi. Organismo vivente del regno dei funghi, compare per la prima volta in letteratura nell’Antico Testamento: «Il sacerdote entrerà a esaminare la muffa sui muri. Se presenta incavature verdastre o rossastre… la casa è impura. Deve essere demolita — pietre, travi e tutto l’intonaco — e portata fuori dalla città in un luogo impuro».
Nella tradizione cristiana, la muffa ha simboleggiato impurità, tossicità, perfino peccato. È stata evitata, strofinata via, temuta. Eppure la muffa ha suscitato anche fascinazione — sul piano estetico quanto su quello scientifico. Come le sue spore, prolifera tra le discipline, mettendo in crisi i nostri binarismi fra bellezza e bruttezza, utilità e decadimento.
C’è bellezza nella muffa? Tra filosofia, arte e scienza del decadimento
Guardando da vicino, scorgiamo un organismo antico e tenace che ha attraversato le epoche. Frank M. Dugan, in Fungi in the Ancient World, ricostruisce come i funghi — funghi superiori, muffe, ruggini e lieviti — abbiano contribuito a plasmare le prime civiltà in Europa e nel Vicino Oriente. La muffa ci ricorda la mortalità. Come osserva Levin a Kitty in Anna Karenina di Tolstoj: «Tutta la nostra vita non è che un po’ di muffa sulla crosta di un piccolo pianeta. Eppure immaginiamo di possedere qualcosa di grande — idee, opere! Non sono che granelli di polvere».
Il brutto, l’impuro, attraggono. Già nel 1790 Immanuel Kant affronta le risposte estetiche alla bruttezza nella Critica del Giudizio. Il grottesco esiste in natura e può piacere — per fascinazione verso il corrotto o per la sua utilità. La muffa, deprecata quando è invasiva, viene ammirata quando è messa al servizio dell’uomo: nella scienza, in medicina, in gastronomia.
Dal laboratorio alla tavola: la muffa che guarisce e nobilita la materia
Nel 1928, alla St. Mary’s Hospital Medical School, lo scozzese Alexander Fleming scopre la penicillina osservando una muffa verde — Penicillium notatum — che aveva contaminato una piastra di Petri uccidendo batteri stafilococcici. Quella sostanza diventerà la penicillina, poi sviluppata negli anni Quaranta da Howard Florey ed Ernst Chain in un antibiotico salva-vita. La muffa non solo guarisce: nutre. In formaggi e vini parliamo di muffe nobili. Penicillium candidum crea la crosta bianca di Brie e Camembert. Penicillium roqueforti dona le venature blu a Roquefort e Gorgonzola. I vini botritizzati — Tokaji in Ungheria, Sauternes in Francia o la tedesca Trockenbeerenauslese — si affidano a Botrytis cinerea, la muffa nobile, per concentrare gli zuccheri e approfondire i sapori. Qui la muffa diventa sinonimo di gusto, raffinatezza. Per dirla con Nietzsche, «anche la muffa nobilita».
Intelligenza senza cervello: le forme di vita che pensano attraverso la decomposizione
Oltre al gusto, la muffa suggerisce intelligenza. Audrey Dussutour, biologa al CNRS in Francia, ha dimostrato che il mixomicete Physarum polycephalum — noto come The Blob — esprime una forma rudimentale di cognizione. Pur privo di cervello, si adatta, ricorda, risolve problemi. In un esperimento, i ricercatori disposero fiocchi d’avena su una mappa del Giappone, in corrispondenza delle principali città. La muffa collegò le risorse alimentari tracciando pattern simili alla rete ferroviaria di Tokyo, come se stesse risolvendo un problema di ottimizzazione.
Ideonella sakaiensis: il batterio che mangia la plastica e trasforma l’innaturale in vita
Nel 2016, all’interno di un impianto di riciclo della plastica in Giappone, i ricercatori identificano un organismo che mette silenziosamente in discussione il confine tra artificiale e naturale. È un batterio, poi chiamato Ideonella sakaiensis, capace di degradare il polietilene tereftalato (PET) — una delle plastiche più diffuse al mondo. Lungi dall’essere un’eccezione isolata, questo organismo microscopico rivela una notevole strategia metabolica: si nutre di plastica. Secernendo due enzimi specializzati, scompone le lunghe catene polimeriche in molecole organiche di base, che poi assorbe e metabolizza come fonte di energia. Il fenomeno non è isolato.
Negli ultimi anni, gli scienziati hanno scoperto decine di microrganismi con capacità analoghe. Alcuni prosperano in terreni industriali, altri in sedimenti marini, discariche, perfino nell’intestino di certe larve. La natura, a quanto pare, sta silenziosamente ripiegando la plastica nei propri cicli di degrado e rinnovamento. Dalla sua scoperta, Ideonella sakaiensis è divenuta oggetto di intensa ricerca biochimica. In laboratorio i suoi enzimi sono stati ingegnerizzati per aumentarne l’efficienza e ampliarne lo spettro d’azione. Alcune varianti oggi agiscono su plastiche più cristalline e resistenti — come quelle delle bottiglie — in una frazione del tempo iniziale.
Altri scienziati hanno trasferito il “progetto genetico” del batterio in microrganismi marini a rapida crescita, permettendo agli enzimi di operare anche in condizioni saline. Si stanno sviluppando consorzi microbici sperimentali che combinano batteri e funghi per attaccare in concerto compositi plastici complessi. Le possibilità vanno oltre la biodegradazione, spingendosi verso una piena assimilazione biologica. In ciò, Ideonella diventa cugina simbolica della muffa. Come Penicillium notatum che trasforma una piastra contaminata nell’alba degli antibiotici, o Botrytis cinerea che fa del grappolo appassito oro liquido, Ideonella sakaiensis trasforma in nutrimento ciò che si riteneva indigeribile e permanente. Non distrugge la plastica; la metabolizza. La integra in una nuova ecologia.
La lezione della muffa: dal marciume alla rigenerazione, un’ecologia della trasformazione
Questi microbi “mangiaplastica” offrono più di una potenziale soluzione all’inquinamento. Propongono una visione più profonda dell’ecologia stessa — non fondata sulla cancellazione o rimozione, ma sull’incorporazione. La decomposizione diventa una forma di creatività. Il batterio non è un distruttore; è un compositore di nuovi ordini chimici. In quanto tale, prosegue l’opera della muffa: lenta, invisibile e infinitamente adattiva. Un’alchimista dei margini. Lungi dall’essere una minaccia, il decadimento diventa un processo di traduzione.
Come la muffa che incrosta i frutti nelle nature morte di Chardin o i mixomiceti che mappano la logica delle città, Ideonella sakaiensis rivela che l’intelligenza della natura opera tanto per dissoluzione quanto per costruzione. Perfino la plastica — il nostro manufatto più innaturale — non è più immune all’appetito della vita. L’osservazione di Hebbel — che un giorno potremmo aver bisogno di una lente per riconoscere cos’era una foresta — si fa sempre più pregnante. La muffa, scrutata da vicino, rivela un’intelligenza ecologica che la vita moderna ignora a proprio rischio.
Il micelio, rete fungina sotterranea, facilita la comunicazione e sostiene i boschi collegando le radici e condividendo risorse. La muffa non è un nemico da estirpare, ma un vettore d’informazione ed equilibrio. Un custode microscopico della vita. Contemplare la muffa è guardare nella logica dell’entropia, ma anche nella resilienza della natura. È un mondo non di declino, ma di reintegrazione. Un marciume vellutato che ci insegna ad accettare il cambiamento e ad abbracciare la trasformazione — non solo nella natura, ma in noi stessi.

photo from the phytopathology research group at the Laimburg Research Center, thanks to Vera Christandl and Agnese Martinelli.
